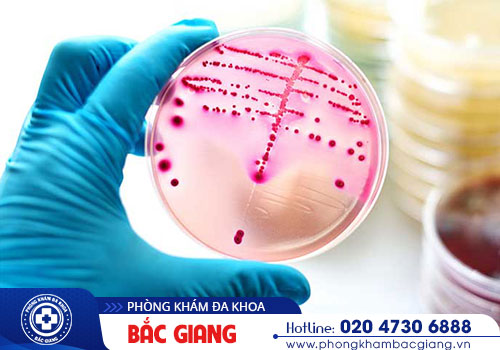
Xét nghiệm bệnh lậu ở đâu uy tín?

Để phát hiện bệnh lậu sớm và kịp thời can thiệp điều trị bệnh thì sau khi phơi nhiễm bệnh, hoặc khi có những dấu hiệu mắc bệnh, người bệnh nên đến ngay những cơ sở chuyên khoa đáng tin cậy để tiến hành xét nghiệm. Vậy xét nghiệm bệnh lậu ở đâu uy tín?
TỔNG QUAN VỀ BỆNH LẬU
Bệnh lậu là căn bệnh xã hội gây ra bởi lậu cầu khuẩn. Bệnh lý này có thể gặp phải ở mọi đối tượng nhất là những người đang trong độ tuổi sinh sản. Đặc biệt, bệnh lây lan chủ yếu qua đường quan hệ tình dục không an toàn, truyền từ mẹ sang con hay qua đường máu.
Là căn bệnh nguy hiểm có tốc độ lây lan nhanh, nếu không được phát hiện và chữa trị sớm, bệnh lậu sẽ gây ra ảnh hưởng nghiêm trọng tới sức khỏe, khả năng sinh sản của bệnh nhân, nghiêm trọng hơn còn đe dọa tới tính mạng của người bệnh.
Tùy vào từng giai đoạn mà bệnh lậu sẽ có các biểu hiện khác nhau. Sau đây là các triệu chứng chung khi mắc bệnh lậu:
![]() Bộ phận sinh dục chảy máu bất thường.
Bộ phận sinh dục chảy máu bất thường.
![]() Hậu môn ngứa, chảy máu.
Hậu môn ngứa, chảy máu.

Bệnh lậu là nỗi ám ảnh của nhiều bệnh nhân
![]() Vùng háng sưng đau.
Vùng háng sưng đau.
![]() Đau họng.
Đau họng.
![]() Đi tiểu ra máu.
Đi tiểu ra máu.
Khi xuất hiện những dấu hiệu bất thường trên, hoặc nghi ngờ mình mắc bệnh lậu, bạn nên nhanh chóng tìm kiếm địa chỉ xét nghiệm bệnh lậu ở đâu uy tín để được chẩn đoán bệnh sớm và có phác đồ hỗ trợ điều trị hiệu quả.
Để tìm hiểu đầy đủ các thông tin về bệnh lậu, hãy click ngay vào Khung chat bên dưới để được các chuyên gia tư vấn trực tuyến

VÌ SAO CẦN PHẢI XÉT NGHIỆM BỆNH LẬU?
Xét nghiệm bệnh lậu là một loại xét nghiệm quan trọng, giúp bác sĩ chẩn đoán chính xác rằng bạn có đang mắc bệnh lậu hay không. Hơn nữa, việc chủ động đi xét nghiệm bệnh lậu sớm còn mang tới nhiều lợi ích như:
![]() Nhằm xác định bệnh chính xác về mức độ, tình trạng, từ đó có hướng hỗ trợ chữa trị bệnh kịp thời.
Nhằm xác định bệnh chính xác về mức độ, tình trạng, từ đó có hướng hỗ trợ chữa trị bệnh kịp thời.
![]() Phòng tránh lây lan bệnh cho người khác.
Phòng tránh lây lan bệnh cho người khác.
Xét nghiệm bệnh lậu sớm mang lại nhiều lợi ích
![]() Hỗ trợ sàng lọc các căn bệnh xã hội khác như mụn rộp sih dục, sùi mào gà.
Hỗ trợ sàng lọc các căn bệnh xã hội khác như mụn rộp sih dục, sùi mào gà.
![]() Ngăn bệnh tiến triển nặng, dẫn tới các biến chứng nghiêm trọng.
Ngăn bệnh tiến triển nặng, dẫn tới các biến chứng nghiêm trọng.
![]() Giúp tiết kiệm thời gian, chi phí điều trị vì bệnh ở giai đoạn đầu, chưa có biến chứng nghiêm trọng, việc chữa trị không gặp nhiều khó khăn.
Giúp tiết kiệm thời gian, chi phí điều trị vì bệnh ở giai đoạn đầu, chưa có biến chứng nghiêm trọng, việc chữa trị không gặp nhiều khó khăn.
VẬY XÉT NGHIỆM BỆNH LẬU Ở ĐÂU UY TÍN?
Tại Bắc Giang cũng như nhiều tỉnh thành lân cận khu vực miền Bắc, nếu bạn chưa biết xét nghiệm bệnh lậu ở đâu uy tín thì có thể an tâm lựa chọn Phòng khám Đa Khoa Bắc Giang tọa lạc ở địa chỉ 357-359 Nguyễn Thị Minh Khai, P.Dĩnh Kế, TP.Bắc Giang.
Phòng khám Bắc Giang là một trong những cơ sở chuyên khoa đi đầu trong việc ứng dụng các kỹ thuật hiện đại vào tiến hành xét nghiệm cũng như hỗ trợ điều trị các bệnh xã hội, trong đó có bệnh lậu. Sau khi chẩn đoán xác định rõ tình trạng, mức độ của bệnh, bác sĩ chuyên khoa của phòng khám sẽ đưa ra phương pháp hỗ trợ điều trị phù hợp đối với từng trường hợp bệnh nhân. Từ đó, mang tới hiệu quả điều trị cao, hỗ trợ nhiều bệnh nhân nhanh chóng đẩy lùi bệnh, hạn chế tối đa nguy cơ bệnh tái phát.
Bên cạnh đó, phòng khám còn được đánh giá cao bởi những ưu điểm nổi bật về chất lượng khám chữa bệnh như:
![]() Quy trình xét nghiệm chẩn đoán và hỗ trợ điều trị bệnh được tiến hành bởi các bác sĩ chuyên khoa có tay nghề giỏi, kinh nghiệm dày dặn nhằm đảm bảo kết quả chính xác và hiệu quả chữa trị tốt.
Quy trình xét nghiệm chẩn đoán và hỗ trợ điều trị bệnh được tiến hành bởi các bác sĩ chuyên khoa có tay nghề giỏi, kinh nghiệm dày dặn nhằm đảm bảo kết quả chính xác và hiệu quả chữa trị tốt.
![]() Hệ thống máy xét nghiệm tiên tiến, hiện đại, được kiểm định chất lượng thường xuyên, đảm bảo hoạt động tốt, cho kết quả xét nghiệm chính xác.
Hệ thống máy xét nghiệm tiên tiến, hiện đại, được kiểm định chất lượng thường xuyên, đảm bảo hoạt động tốt, cho kết quả xét nghiệm chính xác.
.jpg)
Bệnh nhân được tư vấn chi tiết về kết quả xét nghiệm
![]() Phòng xét nghiệm được xây dựng khang trang, rộng rãi, thường xuyên được khử khuẩn.
Phòng xét nghiệm được xây dựng khang trang, rộng rãi, thường xuyên được khử khuẩn.
![]() Đơn vị hoạt động cả trong và ngoài giờ hành chính từ 8h00 – 20h00 tất cả các ngày trong tuần, không nghỉ kể cả cuối tuần hay lễ, Tết, luôn sẵn sàng phục vụ bệnh nhân. Đặc biệt không tăng phí ngoài giờ hành chính.
Đơn vị hoạt động cả trong và ngoài giờ hành chính từ 8h00 – 20h00 tất cả các ngày trong tuần, không nghỉ kể cả cuối tuần hay lễ, Tết, luôn sẵn sàng phục vụ bệnh nhân. Đặc biệt không tăng phí ngoài giờ hành chính.
![]() Chi phí xét nghiệm, thăm khám cũng như hỗ trợ bệnh lậu sẽ được niêm yết đầy đủ trên bảng giá, nằm trong khung giá mà cơ quan chức năng quy định. Vì vậy, không lo bị thu phí cao hay phát sinh bất kì khoản phí nào khác ngoài chi phí đã thông báo với người bệnh trước khi khám chữa bệnh.
Chi phí xét nghiệm, thăm khám cũng như hỗ trợ bệnh lậu sẽ được niêm yết đầy đủ trên bảng giá, nằm trong khung giá mà cơ quan chức năng quy định. Vì vậy, không lo bị thu phí cao hay phát sinh bất kì khoản phí nào khác ngoài chi phí đã thông báo với người bệnh trước khi khám chữa bệnh.
![]() Chế độ bảo mật thông tin tại phòng khám cũng được đánh giá cao. Toàn bộ hồ sơ bệnh án, thông tin cá nhân của người bệnh sẽ được bảo mật an toàn trên hệ thống, không lo bị rò rỉ ra bên ngoài, bảo vệ cuộc sống riêng tư của bệnh nhân.
Chế độ bảo mật thông tin tại phòng khám cũng được đánh giá cao. Toàn bộ hồ sơ bệnh án, thông tin cá nhân của người bệnh sẽ được bảo mật an toàn trên hệ thống, không lo bị rò rỉ ra bên ngoài, bảo vệ cuộc sống riêng tư của bệnh nhân.
Hy vọng những thông tin mà bài viết vừa cung cấp trên đây, đã giúp bạn đọc tìm được địa chỉ xét nghiệm bệnh lậu ở đâu uy tín. Nếu bạn còn câu hỏi thắc mắc nào khác về bệnh lý này, hãy nhanh chóng liên hệ số Hotline 020 4730 6888 hoặc nhấp chuột vào Bảng tư vấn dưới đây để được hỗ trợ giải đáp thông tin nhanh chóng và hoàn toàn miễn phí.
Đặt lịch hẹn thăm khám trên KHUNG TƯ VẤN online để ĐƯỢC hưởng ưu đãi:
![]() Được ưu tiên thăm khám ngay, không cần bốc số và chờ đợi.
Được ưu tiên thăm khám ngay, không cần bốc số và chờ đợi.
![]() Được miễn phí sổ khám bệnh.
Được miễn phí sổ khám bệnh.
![]() Được giảm chi phí cận lâm sàng.
Được giảm chi phí cận lâm sàng.
![]() Được yêu cầu, chỉ định bác sĩ chuyên khoa trực tiếp thăm khám và điều trị.
Được yêu cầu, chỉ định bác sĩ chuyên khoa trực tiếp thăm khám và điều trị.
![]() Được hỗ trợ đi lại, nơi ở đối với những bệnh nhân ở xa.
Được hỗ trợ đi lại, nơi ở đối với những bệnh nhân ở xa.
![]() Được theo dõi sức khỏe, chăm sóc online sau thăm khám và điều trị.
Được theo dõi sức khỏe, chăm sóc online sau thăm khám và điều trị.

Đặt Hẹn Hôm Nay, Giảm Phí Điều Trị 30% Phí Phẫu Thuật 30%. LIÊN HỆ NGAY!

